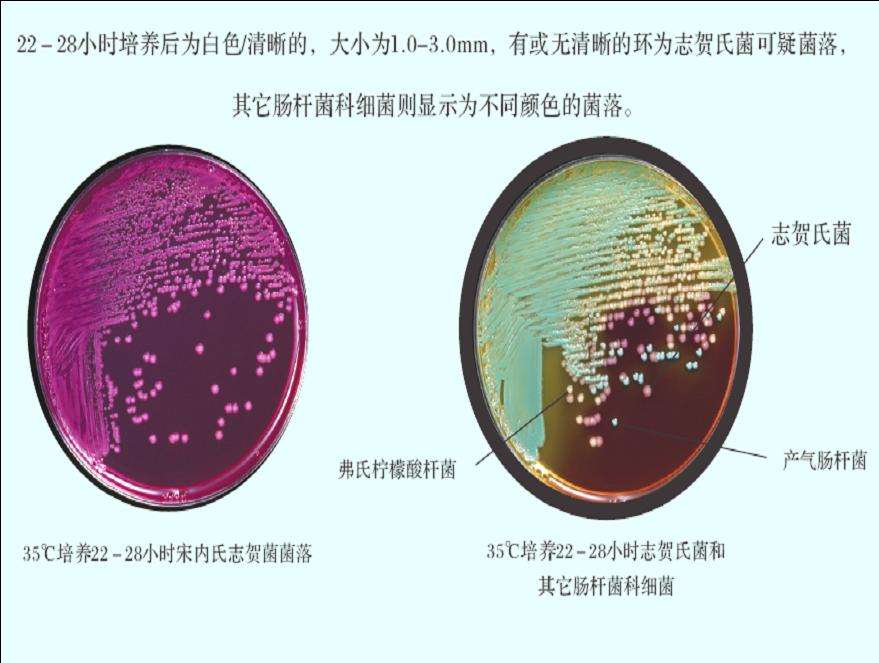
产品细节图片1

相关产品推荐更多 >
万千商家帮你免费找货
0 人在求购买到急需产品
- 详细信息
- 文献和实验
- 技术资料
- 库存:
9999
- 英文名:
Guangzhou Jianlun Biotechnology Co., Ltd
- 供应商:
健仑生物
- 保存条件:
2-30度
- 规格:
10T盒
志贺氏杆菌抗体-Ab快速检测卡(胶体金法)说明书
日本生研的细菌诊断试剂世界知名。其细菌分型抗血清的产品基本上垄断临床微生物市场和日本的公共卫生检测实验室。广州健仑生物科技公司有相关各类血清产品,包括志贺氏菌,大肠埃希氏菌,沙门氏菌,大肠杆菌,军团菌,李斯特菌等。详情可直接联系公司工作人员。
志贺氏菌抗原快速检测卡是一种基于免疫层析原理的快速检测试剂,用于定性检测样本中的志贺氏杆菌抗体。以下是该检测卡的详细介绍:
用途
该检测卡适用于预防控制、出入境检验检疫以及基层单位的腹 泻病原监测。通过快速检测样本中的志贺氏杆菌抗体,有助于及时发现和诊断志贺氏菌感染,为疫情防控提供有力支持。
检测原理
志贺氏杆菌抗体快速检测卡采用胶免疫层析技术,利用抗原与抗体特异性结合的原理,通过层析作用使样本中的志贺氏杆菌抗体与试剂中的胶标记抗原结合,形成复合物并显示在检测线上。通过观察检测线的显色情况,可以判断样本中是否存在志贺氏杆菌抗体。
检测方法
.准备试剂:打开检测卡包装,取出检测卡并平放于台面。确保检测卡处于干燥、清洁的状态。
.加样:使用滴管或吸管将处理后的样本滴加到检测卡的加样孔中。加样量应严格按照说明书要求执行,避免过多或过少导致检测结果不准确。
.观察结果:在规定的时间内(通常为15分钟内),观察检测卡上的显色反应。根据说明书提供的结果判读标准,判断样本中是否存在志贺氏杆菌抗体。
以下是健仑生物部分检测试剂:
三日疟 原虫检测试剂盒(胶体层析法)
疟 疾抗原快速检测试剂
登革病毒抗体检测试剂
寨卡病毒igg检测试剂盒
基 孔肯雅热抗体igg检测试剂盒
黄 热病毒抗体检测试剂盒
汉 坦病毒IgG/IgM检测试剂盒
登革病毒ns1抗原检测试剂
登革igg/igm抗体检测试剂盒
寨卡病毒igm抗原检测试剂盒
基 孔肯雅热抗体igm检测试剂盒
埃博 拉病毒抗原快速检测试剂盒
伊波拉病毒抗原快速检测试剂盒
黄 热病毒IgG、igm抗体检测试剂盒
沙门氏菌检测试剂条S 免疫层析法 询价
沙门氏菌检测试剂条 免疫层析法 询价
志贺氏杆菌检测试剂条 免疫层析法 询价
痢 疾志贺氏菌检测条 免疫层析法 询价
沙门氏菌检测条免疫层析法 询价
certest痢 疾志贺氏菌检测卡原配说明书
志贺氏杆菌抗体-Ab快速检测卡
痢 疾志贺氏菌检测试纸条(免疫层析法)
痢 疾杆菌快速检测卡
风险提示:丁香通仅作为第三方平台,为商家信息发布提供平台空间。用户咨询产品时请注意保护个人信息及财产安全,合理判断,谨慎选购商品,商家和用户对交易行为负责。对于医疗器械类产品,请先查证核实企业经营资质和医疗器械产品注册证情况。
文献和实验的同时,也将会大大提高其在诊断试剂的地位。胶体金快速诊断产品:人类免疫缺陷病毒抗体诊断试剂盒(胶体金法)和14种生物安全性快速检测试剂。4. 北京贝尔生物工程有限公司, 是一家中外合资的股份制企业,专业生产体外诊断试剂。公司注册于北京市大兴经济技术开发区内,厂区占地十余亩,拥有1200 m2的GMP生产车间,于2005年通过国家食品药品监督管理局的GMP认证,2008年3月通过体外诊断试剂质量体系考核认证产品有:TORCH四联卡(金标),人绒毛膜促性腺激素诊断试剂(胶体金法)。5. 北京
个复合物(Ab1-Au-Ag-Ab2)而富集在检测区。由于胶体金自身显色而形成红色的质控线。该方法由于简便、快速、特异性、敏感性好,结果直观等优点,得到了空前广泛的发展和应用。 与其他检测技术比较,应用免疫胶体金快速检测技术时,样品不需要特殊处理,试剂和样本用量极小,样本量可低至1 μL~2 μL;既可用于抗原检测,也可用于抗体检测,检测时间大大缩短,也不需荧光显微镜、酶标检测仪等贵重仪器,试验结果可长期保存。但该技术一般作为定性,不易定量,大批量的集约性的操作,不如ELISA快而方便[6]。 二
鉴定及抗体筛查 A、B、O及Rh血型卡,不规则抗体筛查卡均由长春博讯公司生产,Pyrene试剂由台湾Bs公司生产,A、B、O及Rh血型鉴定及不规则抗体筛查,均采用微柱凝胶免疫测技术,交叉配血采用凝聚胺法,均严格按说明书操作。 23结果 例1,A型Rh(D)阳性;例2,O型Rh(D)阳性;例3,AB型Rh(D)阳性,抗体筛查均未发现不规则抗体。例1共输A型Rh+红细胞悬液4U,例2共输O型Rh+红细胞悬液2U,例3共输AB型Rh+红细胞4U,均未发生不良输血反应。 上述三例用肝素
技术资料暂无技术资料 索取技术资料










